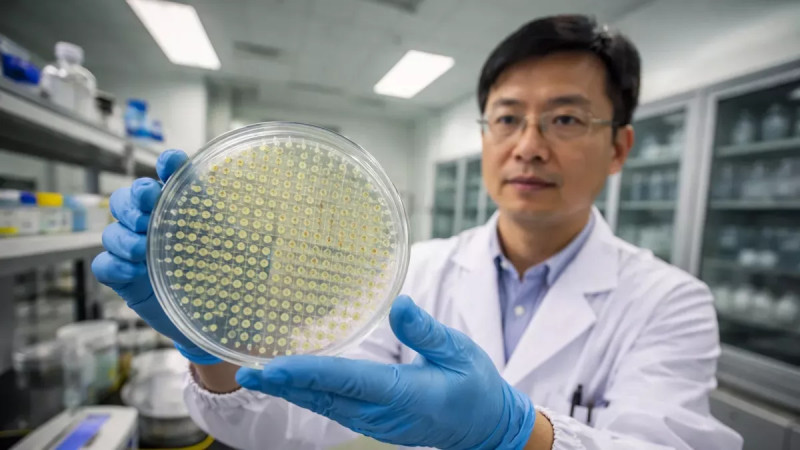
Link Preview

Tiscali.cz
#VolbyUSA #DonaldTrump #Republikáni

#superpotravina #zdraví #výživa

#rakovina #výzkum #mikrogravitace




#exoplanety #životmimoZemi #astrofyzika


#Neom #městoBudoucnosti #technologie

#Námraza #ZimníPočasí #Výstraha

#UměláInteligence #OchranaObětí #Deepfake

#MobilníPlatby #Podvody #Bezpečnost

#robotika #softwarovyVyvoj #inovace

#politika #demonstrace #českárepublika


#Slovensko #politika #rezignace




#Kuba #USA #zahraničníPolitika

#životnípříběh #lidskádůstojnost #asistivnítechnologie

#onkologie #prevence #uměláinteligence



#transplantace #psychologie #epigenetika

#Challenger #KosmickéLety #Vzdělávání

#transparentnost #střetzájmu #korupce

#politika #vyslovenínedůvěry #Českárepublika

#letectví #tragédie #Smartwings

#ŽenyVeVědě #Matematika #Technologie


#rozpočet #národnírozpočtovárada #financování


#TunguzskáExploze #VesmírnéHrozby #PlanetárníObrana

#vesmír #satelity #technologie



#politika #vydírání #kompromisy

#MichaelSchumacher #Formule1 #ZdravotníStav


#elektronickýodpad #recyklace #zlato

#ŽeleznáRuda #Austrálie #Geologie

#kriminalita #vražda #tragédie

#ArtemisII #kosmonautika #Měsíc


#extrémnílezení #AlexHonnold #životnívýzvy

#Archeologie #Architektura #Vitruvius

#evoluce #hominidi #zkameněliny


#CzechoslovakGroup #ČEZ #akcie

#ŽelezničníDoprava #Inovace #Japonsko



#technologie #soukromí #sledování


#spánek #nočníprobuzení #zdraví


#EvropskáUnie #USA #obchodnívztahy

#dezinformace #psychologie #kritickémyšlení

#pravěkéumění #archeologie #historie


#AquaTofana #historie #ženskápráva

#OpenAI #UměláInteligence #Reklama


#PatrikHezucký #O2Aréna #Vzpomínky


#Intersex #Identita #LidskáPráva

#Egyptologie #Nefertiti #ZahiHawass

#Europol #OrganizovanýZločin #SyntetickéDrogy

#DopravaZdarma #Eshop #OnlineNakupy


#ValentinoGaravani #móda #hauteCouture


#DonaldTrump #politika #diplomacie

#tragédie #bezpečnost #samospráva


#Antarktida #klimatickézměny #ledovce

#IranProtests #HumanRights #Genocide

#archeologie #historie #lovvelryb


#archeologie #historie #technologie

#LunárníDovolená #VesmírnýTurismus #GRUSpace

#čtení #duševnízdraví #dlouhověkost

#Materiály #Technologie #Inovace

#propuštění #politickévězně #Venezuela



#KybernetickáBezpečnost #EU #ČínskéTechnologie


#Ukrajina #ČeskáRepublika #MuničníIniciativa

#JanPalach #VáclavskéNáměstí #památka

#FreddieMercury #tajnádcera #Queen

#pracovnipodminky #vykoristovani #hracky


#SyndromAutopivovaru #Zdraví #Mikrobiom

#neandertálci #archeologie #historie

#Ukrajina #energetika #Zelenskyj

#technologie #budoucnost #zdraví

#Kosmetika #KlamaváReklama #Zdraví

#Munchausen #domácí_týraní #psychologie

#Auto #GenderovéRovnosti #Sociologie

#historie #archeologie #námořnídoprava

#TeoretickáFyzika #Vesmír #Inovace


#alkohol #bezpečnost #rodičovství

#podvody #finančníbezpečnost #senioři

#SedmáGenerace #IndiánskáFilozofie #Odpovědnost

#nosnísprays #závislost #zdraví

#MuničníIniciativa #ČeskéFirmy #Bezpečnost

#Technologie #Biologie #Budoucnost

#kritickemysleni #dezinformace #pravda


#EkonomickýNátlak #MezinárodníVztahy #Sankce



#LeonardoDaVinci #DNA #historieUmění



#Cestování #HotelovéPokoje #Dovolená

#zuby #ParkinsonovaNemoc #mikrobiom


#Tamagotchi #nostalgie #digitálnímazlíček


#GeneraceBeta #Budoucnost #Technologie

#LétajícíTaxi #VzdusnaDoprava #MěstskáMobilita

#Venezuela #Sankce #MezinárodníPrávo


#zdraví #vitaminC #klementinky

#stomatologie #zdraví #zubnípéče

#archeologie #historie #Bretanje

#Cestování #InKarta #SlevyProSeniory

#eZdravotnictví #digitalizace #zdravotnípéče


#eZdravotnictví #elektronickéŽádanky #digitalizaceZdravotnictví

#lázeňskýpobyt #senior #regenerace

#elektronickézdravotnictví #eHealth #digitalizacezdravotnictví


#Společnost #ObčanskáSoudržnost #Důvěra

#zdravotnictví #pojištění #onkolologie

#superpočítač #neurovědy #simulace

#KybernetickáBezpečnost #EtickýHacking #TechnologieProDívky

#SuchýLeden #ZdravýŽivotníStyl #PauzaOdAlkoholu

#přátelství #vzpomínky #tradice

#teleportace #kvantováfyzika #inovace


#epigenetika #zdraví #rodičovství

#zdravástrava #domácípolévka #jednoduchosť

#BrigitteBardot #film #právaZvířat


#energetika #dynamickytarif #úsporyenergii

#marihuana #dospívající #psychika

#PracovníRovnováha #KvalitaŽivota #DuševníZdraví

#zdraví #toaleta #močovýměchýř

#Zdraví #MobilníAplikace #Prevence

#zdraví #osobnípříběh #vzdělání

#penzijníreforma #důchody #sociálnípolitika

#důchody #valorizace #sociálnízabezpečení

#TýdenSportuZdarma #Praha #AktivníŽivot

#DigitálníBezpečnost #Workshopy #Senioři

#kosmonautika #inspirace #dostupnost


#létajícíauta #technologie #elektromobilita



#inteligence #neurověda #osobnírozvoj



#karagenan #potravinářství #zdraví

#psychologie #vzdělávání #osobnírozvoj


#astronomie #komety #mezihvězdnýobjekt

#rozpočty #krajskéinvestice #hospodářství


#psychedelickáterapie #psilocybin #duševnízdraví





#rakovina #zdraví #psychologie

#historie #genetika #Čingischán

#SerenaWilliams #Sebepřijetí #ŽenskýSport

#CenovéBrzdy #ETS2 #Udržitelnost

#VětrnáEnergie #ObnovitelnéZdroje #Ralsko

#nezapomenej #bezpečnostdětí #únosdětí

#udržitelnost #ekologie #inovace


#ÚsporaEnergie #ChytréTechnologie #Udržitelnost

#dinosauři #paleontologie #Bolívie

#infrastruktura #Norsko #dědictví

#energetickénápoje #zdraví #kofein


#TréninkMozku #Senioři #KognitivníZdraví

#ŽenyVeVůdcovství #Forbes #GlobálníVliv

#SanJosé #námořníhistorie #archeologie

#medicína #inovace #mikroroboti



#Vláda #Politika #Zdravotnictví

#Vánoce #SeniorskéAktivity #Společnost

#JiřinaBohdalová #rodina #prababička

#thrifting #sekáče #druhášance

#ObezitaZvířat #VeterinárníLékařství #GLP1

#zdraví #psi #intuitivníchování

#MatthewPerry #Závislost #DuševníZdraví

#MH370 #leteckákatastrofa #pátrání

#slevyprosenory #malepodniky #zdravotnipomucky

#metabolismus #hnědýtuk #zdraví

#Kaufland #slevy #předvánočnínákupy

#JiříProcházka #Rodina #Otcovství

#UměláInteligence #Genetika #Diagnostika

#severskastrava #udrzitelnost #zdraví























































